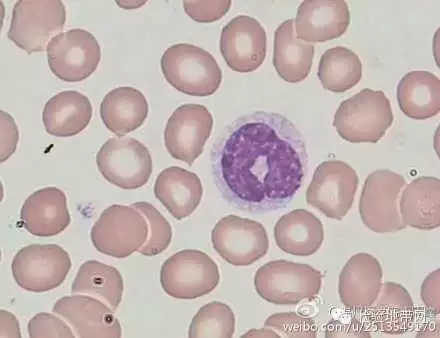
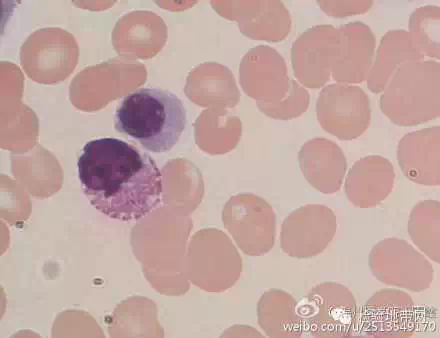

第十二章细胞凋亡与检测技术 ppt download
转贴 经典帖 看图识血细胞第七期 共50张 临床检验医学讨论版 丁香园论坛

c 细胞浆染色过深 图片欣赏中心 急不急图文 jpjww com

www pathology home com

转贴 经典帖 看图识血细胞第七期 共50张 临床检验医学讨论版 丁香园论坛

每日頭條

asianbeautywholesale com

アザン染色 azan stain 結合組織の染色

搜狐
转贴 经典帖 看图识血细胞第七期 共50张 临床检验医学讨论版 丁香园论坛

实验诊断 ppt download

內膜系統 维基百科 自由的百科全书

食檢乙級 酸性色素之分離與鑑別 澎湖科技大學食科系黃鈺茹老師 youtube

与同学谈09届高三生物第二轮复习 ppt download

图 发育不良痣 皮肤病学 天山医学院

染色液 上海尚宝生物科技有限公司

染色色素素材模板 染色色素图片下载 小麦优选

爱问共享资料

www pathology home com

壹讀

c 细胞浆染色过深 图片欣赏中心 急不急图文 jpjww com

組蛋白 概述 組成部分 合成修飾 成分 分類特徵 醫學套用 預測 調控 中文百科全書

itw01

taobao
You May Like